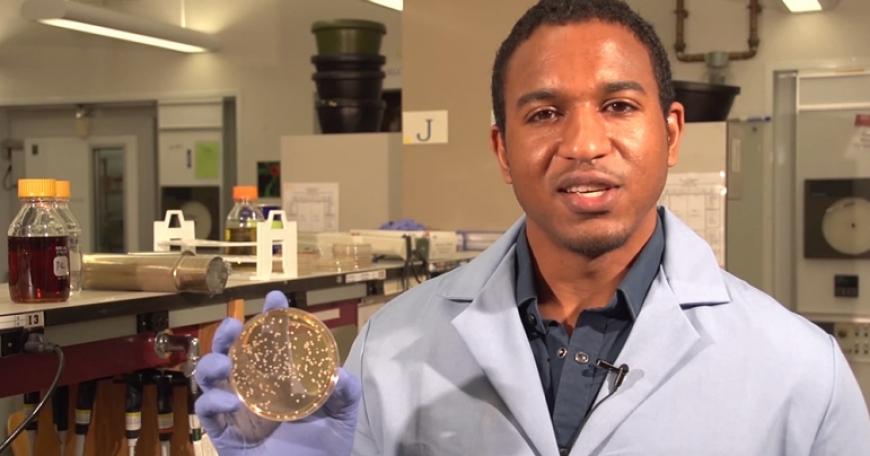
MIT Faculty

MITx version of introductory biology class has deep roots
The MIT introductory biology course now being offered online through edX is simultaneously something old and something new: a version of a beloved MIT course that for decades has been taught by senior faculty to packed lecture halls, and the latest offering of the interactive learning platform launched less than a year ago by MIT and Harvard University.
MIT’s 7.00x (Introduction to Biology: “The Secret of Life”), which began March 5 and runs for 12 weeks, is one of three new courses offered this semester through edX. There are now six MIT edX courses in total.
The online course is taught by senior members of the MIT Department of Biology: Eric Lander and Graham Walker.
“It gives us a chance to rethink the course and to think about new ways to use electronic media at MIT, and that’s pretty exciting,” says Lander, a professor of biology who is also director of the Broad Institute.
This semester, there are 15 new courses on edX — including the first offerings in the humanities and social sciences — from MITx, HarvardX and BerkeleyX, in addition to reprises of 10 existing courses from these three universities. Courses on edX have attracted more than 700,000 registrants from around the world and are attracting about 100,000 more each month.
Even though the biology course was retooled for the Web, it aspires to capture the feel of the course that is taught on campus.
“It’s the whole MIT culture,” Lander says. “In many places, people talk about not having to teach, while at MIT it’s the reverse. The most active faculty here want to be in the classroom.”
Lander, who’ll host the online course, has taught 7.00 to MIT students in the classroom for close to 20 years. He led the Human Genome Project that in the 1990s sequenced human genes, recently won a $3 million Breakthrough Prize in Life Science, and is co-chair of President Barack Obama’s Council of Advisers on Science and Technology.
The introductory biology course has been required at MIT since the early 1990s; for close to 15 years, Lander co-taught it alongside colleague Robert Weinberg, who also recently won a $3 million Breakthrough Prize in Life Science for his research on human cancer genes.
“At many universities, senior faculty are excused from heavy teaching. But their knowledge makes them more effective in the classroom,” Weinberg says. “It’s a feather in MIT’s cap.”
It’s not just Lander and Weinberg teaching 7.00: Sallie “Penny” Chisholm, who received the National Medal of Science in December, also teaches it to MIT freshmen in the classroom.
Having such faculty teach an introductory course in the classroom and online inspires students to learn in a way textbooks cannot, Walker says. “It brings a perspective of someone who’s on the cutting edge. That person teaches in a completely different way,” he says. “What’s in the textbook is old. Eric, for example, mentions things that are happening last week or month. It’s very dynamic and challenging, and students pick up on the excitement.”
The other two courses launching this spring from MIT are 8.02x (Electricity and Magnetism), led by Walter Lewin, a professor emeritus of physics, and 14.73x (The Challenges of Global Poverty), taught by Esther Duflo, the Abdul Latif Jameel Professor of Poverty Alleviation and Development Economics.
Lander says he wanted to teach the online course because it created an opportunity for him and MIT. “It was a chance to rethink this class I loved and taught for 20 years with new technology,” he says.
To make the course work on the Web, Lander, Walker and their biology department colleagues began to meet weekly last September. “We had to think about many, many things,” Lander says, “like how to make people feel like they were in a classroom.”
To do that, an Interrotron — the signature device used by Cambridge documentary filmmaker Errol Morris for getting unsettling close-ups — was set up in the middle of the classroom to record lectures, Lander says. Biographical films were also made of the biology faculty.
The course is designed for students without any background in biology. The faculty team had to rework the curriculum for edX, devise problems for class, make videos of lab work, and make supplemental videos to show how experiments work.
MIT also purchased computer-based protein and gene viewers so online students could view genes and proteins that were previously exhibited in the classroom as models or illustrations. The teachers started using that technology in the classroom, as well.
“Instead of giving them a little toy problem about a human gene, now our students can scan a whole gene using computer-based viewers,” Lander says. “The new technology in our own classrooms is a great thing.”
Walker said the edX course is spurring MIT to adapt technology that will improve the way instructors teach students in the classroom.
“The software and tools will have a revolutionary effect on how we teach on campus,” Walker says.